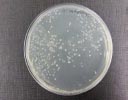

Resultaten
Studie
Gedurende 2 maanden werden bij Interkoi Arendonk de effecten van het product PIP Pond Plus opgevolgd.
Er werd vooral gekeken naar:
- bacteriële samenstelling van het water
- hoeveelheid organisch materiaal (helderheid)
- pH en courante waterparameters zoals hardheid, ammoniak
Beginsituatie (maart 2008)

De analyses van de start van onze studie toonden aan dat nagenoeg alle waterbassins te kampen had met een zeer onstabiele microflora waarin een aanzienlijk aantal ziektekiemen aanwezig waren.
Eindsituatie (april 2008)
Na enkele weken was er een duidelijke positieve trend in de resultaten waar te nemen. Naarmate de goede bacteriën van het product de bovenhand krijgen in het water ontstaat er een stabiel ecosysteem.
Deze voorbeeldgrafiek geeft de evolutie van het risico op Aeromonas (rode lijn), risico op coliformen (blauw), pH (zwarte lijn) en totaal kiemgetal (groene lijn) weer in één van de bassins.

Eindconclusie
Het water krijgt een stabiele en gezonde microbiële gemeenschap; hierdoor zullen de vissen minder stress hebben en zich vooral kunnen concentreren op hun ontwikkeling (groei) in plaats van te moeten vechten tegen ziektekiemen.
Gezonde vissen zijn gelukkige vissen
